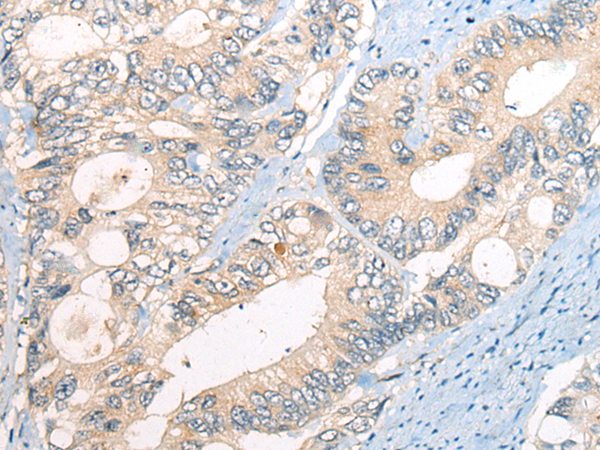
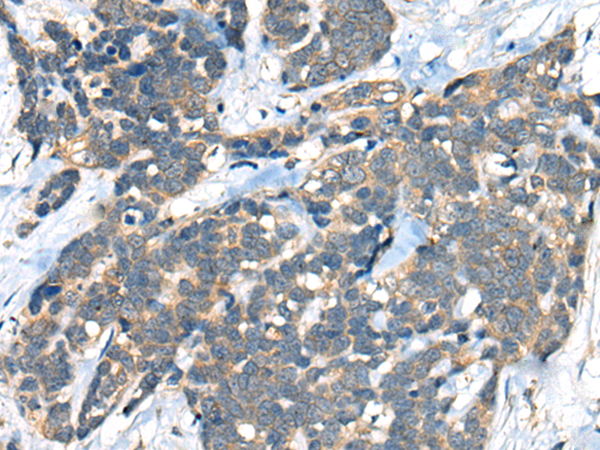

-
分类: 科研抗体货号: P10783别名:应用: WB,IHC反应种属: Human, Mouse
-
分类: 科研抗体货号: P10784别名: CX36; GJA9应用: WB,IHC反应种属: Human, Mouse, Rat
-
分类: 科研抗体货号: P10802别名: DAT; DAT1; PKDYS应用: IHC反应种属: Human, Mouse, Rat
-
分类: 科研抗体货号: P10782别名:应用: WB反应种属: Human, Mouse
-
分类: 科研抗体货号: P10801别名: D4DR应用: WB,IHC反应种属: Human, Mouse
-
分类: 科研抗体货号: P10781别名: CD; GSE; GRD4; ALPS5; CD152; CTLA-4; IDDM12; CELIAC3应用: IHC反应种属: Human, Mouse
-
分类: 科研抗体货号: P10799别名: CCNE; pCCNE1应用: IHC反应种属: Human
-
分类: 科研抗体货号: P10780别名: CTGF; NOV2; HCS24; IGFBP8应用: WB,IHC反应种属: Human, Mouse, Rat
-
分类: 科研抗体货号: P10798别名: KIAK0002应用: WB,IHC反应种属: Human
-
分类: 科研抗体货号: P10812别名: SCZD9; C1orf136应用: IHC反应种属: Human

鄂公网安备42018502007531号
鄂公网安备42018502007531号

